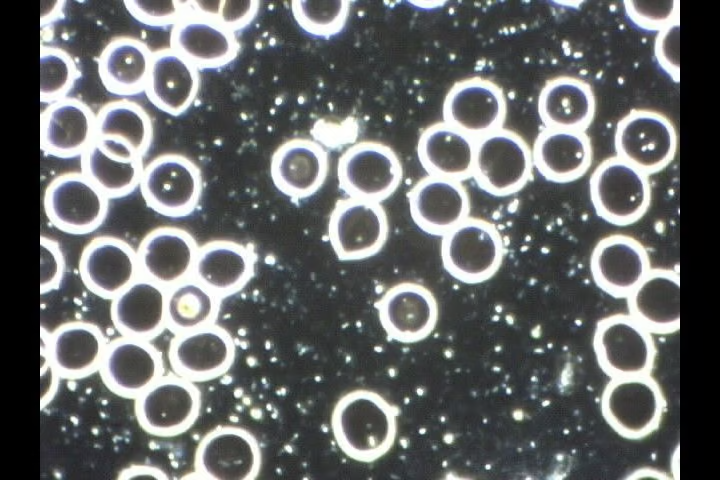

Schmerzen lindern, Immunsystem stärken und erholsamer Schlaf
Angebote
Immunsystem stärken, erholsamer Schlaf & Schmerzen lindern mit dem Schlaf- und Therapiesystem
Schlaf- und Therapiesystem mit Bio-Energiefeld, Bio-Mechanischer Stimulation und Bio-Photonen
weitere Erläuterungen s.u.
weitere Erläuterungen s.u.
Während Sie schlafen, leistet unser Körper ganze Arbeit. Denn die Stunden der Nacht sind seine Regenerationszeit
Schmerzen? Schlafprobleme?
Die Schlafhaltung und somit gesunder Schlaf ist wichtiger als Sie denken.
Unser Orthopädisches, punktelastisches Schlaf- und Therapie System kann sich optimal der anatomischen Form des Körpers anpassen und kann somit Druckentlastung und höchsten Schlafkomfort unterstützen. Die hohe Atmungsaktivität gewährt Langlebigkeit und macht unser Produkt nachhaltig für unserer Umwelt. Gleichzeitig ist es frei von Schadstoffen und gewährt dadurch ein sicheres Gefühl – für einen gesunden und erholsamen Schlaf.
Unser Bezugsstoff „FUSION“ PILATES mit der Blume des Lebens, hier wurden die Eigenschaften zweier natürlicher Rohstoffe – Wolle und Lyocell, mit herausragenden Eigenschaften kombiniert. Dabei bilden die Fähigkeiten der Lyocellfacer wie Feuchtigkeitsaufnahme und Glanz eine ideale Kombination mit Wolle, die für einen komfortablen Griff und die Reduzierung von Gerüchen verantwortlich ist.
Diese Materialkombination ist in der Lage ein trockenes und angenehmes Schlafklima mit besten physiologischen Eigenschaften zu schaffen. Durch die hohe Atmungsaktivität und bestes Schlafklima wird lästigen Hausstaubmilben der Nährboden auf natürlichste Weise entzogen. Zusätzlich ist das Material bei 60° C in der Waschmaschine waschbar und zeichnet sich somit mit höchsten Hygieneeigenschaften aus. Eine weiche und Temperatur ausgleichende Oberfläche sorgt für höchsten Komfort und unterstützt einen angenehmen und erholsamen Schlaf.
Diese Materialkombination ist in der Lage ein trockenes und angenehmes Schlafklima mit besten physiologischen Eigenschaften zu schaffen. Durch die hohe Atmungsaktivität und bestes Schlafklima wird lästigen Hausstaubmilben der Nährboden auf natürlichste Weise entzogen. Zusätzlich ist das Material bei 60° C in der Waschmaschine waschbar und zeichnet sich somit mit höchsten Hygieneeigenschaften aus. Eine weiche und Temperatur ausgleichende Oberfläche sorgt für höchsten Komfort und unterstützt einen angenehmen und erholsamen Schlaf.
Kombination für einen gesunden, erholsamen Schlaf:
Erholung, Entspannung, Regeneration mit therapeutischem Nutzen Tag für Tag und Nacht für Nacht:
Hoher orthopädischer Liegekomfort
Hoch punktelastisch und atmungsaktiv
Hautsympathisch und klimaneutral
Hygienisch und anschmiegsam In allen handelsüblichen Größen, auch in Sondergrößen oder für Wohnmobile erhältlich, Höhe maximal 25 cm Erhältlich mit oder auch ohne Therapiefunktionen.
Ich berate Sie gerne.
Hoher orthopädischer Liegekomfort
Hoch punktelastisch und atmungsaktiv
Hautsympathisch und klimaneutral
Hygienisch und anschmiegsam In allen handelsüblichen Größen, auch in Sondergrößen oder für Wohnmobile erhältlich, Höhe maximal 25 cm Erhältlich mit oder auch ohne Therapiefunktionen.
Ich berate Sie gerne.
Weitere Informationen unter Mobil
+49 1627943714

Bio-Photonen (Lichttherapie)
Die Photonentherapie führt dem Körper, und damit der Zelle, die richtige Information wieder zu und reguliert und reaktiviert sie damit so, dass sie ihre Tätigkeit wieder aufnehmen kann. Die Bio-Photonen-Therapie kann gestörte Zellfrequenzen regulieren und damit verlorene Selbstheilungskräfte wieder herstellen. Sie wirkt auf alle lebenden Zellen des Organismus, deshalb gibt es keine Begrenzung auf bestimmte Krankheitsbilder.
Immer mehr Wissenschaftler bezeichnen die BIO-Photonen-Therapie schon heute als die Informationstherapie der Zukunft.


Bio-Mechanische Stimulation
anerkanntes medizinisches Massageverfahren, löst durch sanfte, aber wirkungsvolle Weise der Schwingungen festsitzende Verspannungen und Verkrampfungen.
Die BIO-Mechanische Stimulation:
- Sorgt für gute Entspannung
- Fördert Ein- und Durchschlafverhalten
- Regt den Lymphfluss positiv an
- Reduziert den Wasserstau in den Beinen
- Strafft das Gewebe, bekämpft Cellulite
- Fördert die Durchblutung
- Lindert Gelenkschmerzen
- Lindert Wirbelsäulen und Ischias-Beschwerden
- Unterstützt die bessere Nahrungsaufnahme für die Bandscheiben
- Fördert das allgemeine Wohlbefinden
- Erhöht die Konzentration durch bessere Entspannung
Die tiefenwirksame Schwingungstherapie spricht die Selbstheilungskräfte des gesamten Körpers an und gilt als Nebenwirkungsfrei.
Bio-Energiefeld
Das pulsierende BIO-Energiefeld System kann besonders sanft und präzise energiearme Zellen in kürzester Zeit zu mehr Leistung anregen.
Wie können pulsierende Energiefelder auf den Körper wirken?
Rhythmisch pulsierende BIO-Energiefelder oder auch pulsierende elektromagnetische Felder genannt, lösen durch elektromagnetische Induktion im Körper verschiedene positive Effekte aus. Insbesondere wird der Ionentransport angeregt und gleichzeitig die Membranspannung der Zellen erhöht. Dadurch erhöht sich das Energie-Niveau der Zellen. Sauerstoff und Nährstoffe können von der Zelle besser aufgenommen und Stoffwechselprodukte einfacher abgeführt werden.
Möglichkeiten der Energiefeld-Therapie
Therapeutische Anwendungen
- Stärkung des Immunsystem bei Infekten und stoffwechselbedingten Allergien.
- Verbesserung der Knochen- und Knorpelstruktur bei Erkrankungen des Bewegungsapperates.
- Aktivierung des Hormonhaushaltes und des damit verbundenen körperlichen und seelischen Wohlbefindens.
- Nacken- und Muskelverspannungen.Neuralgien und Gelenkserkrankungen.
- Kopfschmerzen, Migräne u.v.m.
Vorbeugende Anwendungen
- Erhöhte Sauerstoffversorgung der Zellen.
- Verbesserter Zellstoffwechsel, verbesserte Entgiftung.
- Regeneration und Anti-Stress-Wirkung.
- Gesteigerte körperliche und geistige Leistungsfähigkeit.
- Harmonisierung des vegetativen Nervensystem.
- Kreislaufstabilisierung und Durchblutungsförderung.Veränderung des Blutbildes nach nur 15 Min. BIO-Energiefeld-Anwendung – Dunkelfeld-Mikroskop Aufnahme.Vorher

Veränderung des Blutbildes nach nur 15 Min. BIO-Energiefeld-Anwendung – Dunkelfeld-Mikroskop Aufnahme.
Nachher